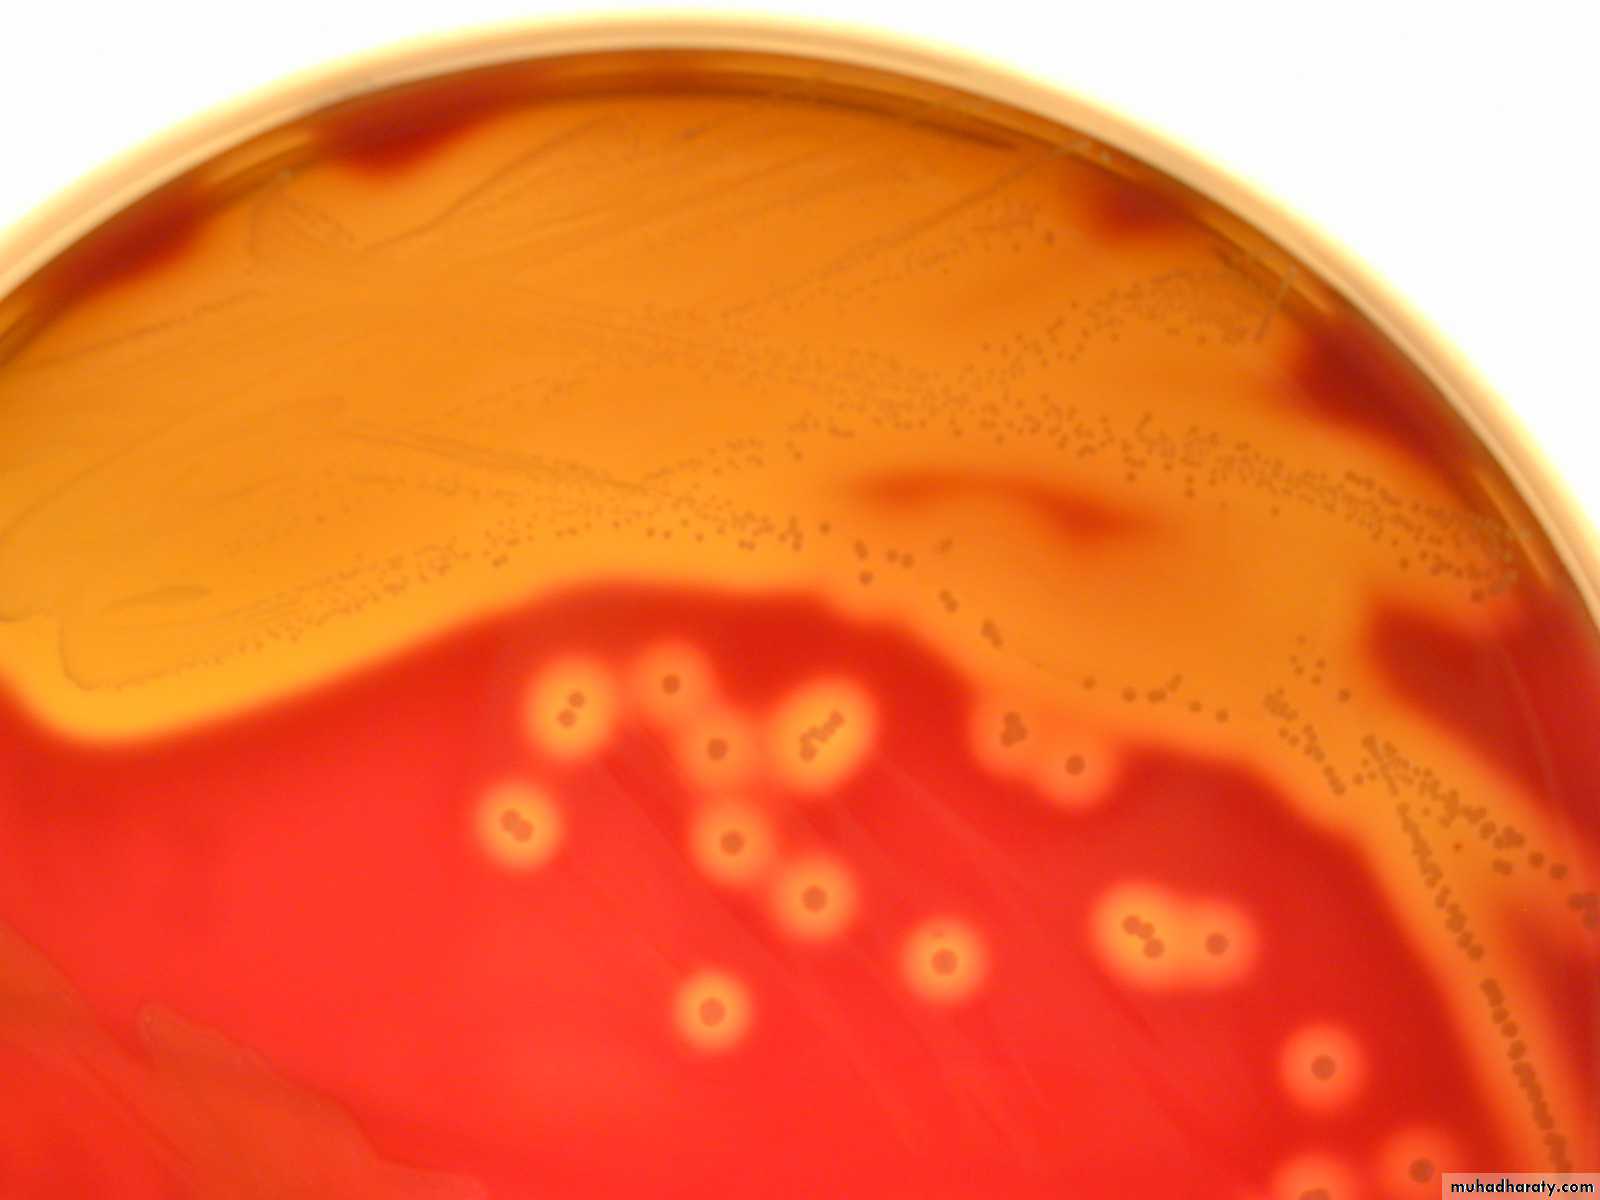
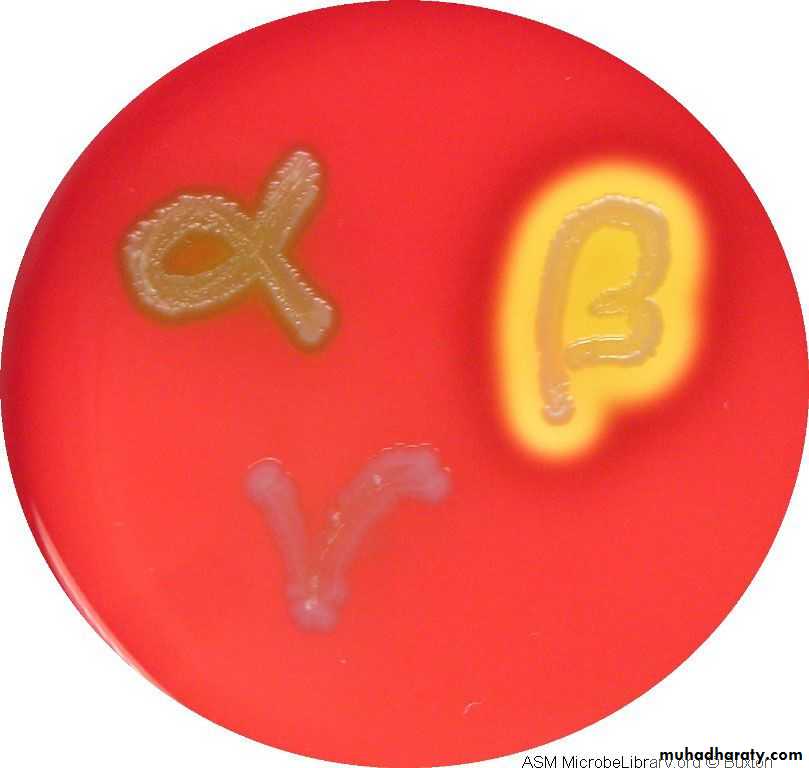

Streptococcus, Pneumococcus and Enterococcus
StreptococcusFamily Streptococcaceae are gram-positive cocci, catalase negative, arranged in pairs or chains.
Streptococcus, Enterococcus and Pneumococcus are the important members of this family.
But, according to the molecular structure, Enterococcus is now reclassified under separate family Enterococcaceae.
StreptococcusClassification
• On the basis of hemolysis, streptococci can be divided into 3 groups:-• α Hemolytic: (Partial or green hemolysis), e.g. Streptococcus viridans, Streptococcus pneumoniae.
• β Hemolytic: (Complete or yellowish hemolysis), e.g. Streptococcus agalactiae and Streptococcus pyogenes.
• γ Hemolytic: (No hemolysis is seen), e.g. Enterococci
StreptococcusClassification
• Lancefield’s grouping (for β haemolytic streptococci)• Based on carbohydrate antigen in cell wall, the β haemolytic Streptococci are further divided into 20 serogroups: Group A to H and K to U.
Streptococcus group A (Streptococcus pyogenes) is further subdivided based on
• 1- Griffith typing: Based on M protein (> 100 M serotypes).
• 2- emm typing: Based on gene coding for M protein, > 124 emm genotypes identified.
Streptococcus pyogenes (Group A)
Virulence Factors (Antigenic Structure).• M Protein:
• Mediates adherence to epithelial cells, inhibits phagocytosis.
• Binds to fibrinogen and neutrophils leadings to release of inflammatory mediators that induce vascular leakage (streptococcal toxic shock).
• M protein is further divided into Class I and Class II. Antibodies to Class I M protein are responsible for pathogenesis of rheumatic fever.
Streptococcus pyogenes (Group A)
• Streptokinase or Fibrinolysin (activates or transform the plasminogen to plasmin) an active proteolytic enzyme that digests fibrin.
Rapid spread: By preventing the formation of fibrin barrier (escape from blood clot).
Therapeutically used in treatment of coronary thrombosis and pulmonary emboli.
• DNase, Deoxyribonuclease (4 types: A, B,C,D). similar to streptokinase facilitate the spread of streptococci in tissue by liquefying pus.
• Hyaluronidase (spreading factor): It breaks down the hyaluronic acid of the tissues, thus helps in the spread of infection along the intercellular space
Streptococcus pyogenes (Group A)
• SPE (Streptococcal Pyrogenic Exotoxin) or Erythrogenic toxin.• 3 Types (SPE A, B and C):
Type A and C are, e.g. of Superantigens.
Type A and C bacteriophage coded,
Type B toxin chromosomal mediated.
• Pathogenic role: Associated with the pathogenesis of scarlet fever, necrotizing fasciitis (Flesh eating disease: death of body’s soft tissue) and streptococcal toxic shock syndrome.
Streptococcus pyogenes (Group A)
• Hemolysins Streptolysin O and Streptolysin S.• Streptolysin O
• Oxygen labile (hence named streptolysin-O )
• Hemolysis is seen only in deep colonies (pour plate)
• It is cytotoxic for neutrophils, platelets and cardiac tissue
• Strongly antigenic
• Antistreptolysin-O antibodies (ASO) are raised in most of the Streptococcal infections and are used as a standard marker for retrospective diagnosis of streptococcal infections (except in glomerulonephritis and pyoderma; where ASO titer is low)
Streptococcus pyogenes (Group A)
• Hemolysins Streptolysin O and Streptolysin S.
• Streptolysin S
• Oxygen stable,
• Causes hemolysis on the surface of blood agar plate,
• It has leucocidal activity.
Streptococcus
Pathogenesis and Clinical Finding• Disease attributable to local infection with Streptococcus pyogenes.
• Streptococcal sore throat (pharyngitis):
In infants and young children, the infection occurs as mild nasopharyngitis with serous discharge and little fever, Middle ear may be involved and cervical lymph node are enlarged.
In older children and adults, the disease is more acute characterized by high fever, intense nasopharyngitis, tonsillitis, with swelling and redness of the mucous membranes. Purulent exudates are usually manifested; tender, enlarged, and painful cervical lymph nodes. Similar clinical picture can be observed in infections with Diphtheria, Gonococci, and Adeno virus.
Pathogenesis and Clinical Finding
• Disease attributable to local infection with S. Pyogenes.• Erysipelas: If the portal of entry is the skin, erysipelas results. Lesions are raised and characteristically red.
Pathogenesis and Clinical Finding
• Disease attributable to local infection with S. Pyogenes.
• Cellulitis: Streptococcal cellulitis is an acute, rapidly spreading infection of the skin and subcutaneous tissues.
• associated with mild trauma, burns, wounds, or surgical incisions.
Pathogenesis and Clinical Finding
• Disease attributable to local infection with S. Pyogenes.• Necrotizing fasciitis (Streptococcal gangrene):
• There is extensive and very rapidly spreading necrosis of the skin, tissues,
• and fascia. sometimes been termed flesh-eating bacteria.
Pathogenesis and Clinical Finding
• Disease attributable to local infection with S. Pyogenes.• Puerperal sepsis (fever):
• If the streptococci enter the uterus after delivery, puerperal fever develops, which is essentially a septicemia originating in the infected wound (endometritis).
• Streptococcal pyoderma: Local infection of superficial layers of skin, especially in children, is called impetigo.
Pathogenesis and Clinical Finding
• Disease attributable to local infection with S. Pyogenes.• Streptococcal sore throat:
Pharyngitis/sore throat (20–40% of all cases)
Pneumonia and empyema: Collection of pus in normal anatomical cavity.
Pathogenesis and Clinical Finding
• Invasive Group A Streptococcal Infections, Streptococcal Toxic Shock Syndrome, and Scarlet Fever.Shock, bacteremia, respiratory failure, and multiorgan failure. Death occurs in about 30% of patients. The infections tend to occur after minor trauma in otherwise healthy persons with several presentations of soft tissue infection. These include necrotizing fasciitis, myositis, and infections at other soft tissue sites; bacteremia occurs frequently.
Bacteremia or sepsis: Infection of traumatic or surgical wounds with streptococci results in bacteremia.
Pathogenesis and Clinical Finding
• Poststreptococcal Diseases (Glomerulonephritis, Rheumatic Fever).• Glomerulonephritis:
It follows skin infection (pyoderma) and often caused by special type M Streptococci.
The disease is initiated by antigen-antibody complexes on the glomerular basement membrane.
There is blood and proteins in the urine, edema, high blood pressure, and urea nitrogen retention.
Some patients develop chronic infection, others die, and the majority recovers completely.
Pathogenesis and Clinical Finding
• Poststreptococcal Diseases (Glomerulonephritis, Rheumatic Fever).• Rheumatic Fever.
• It is the most serious sequela of Streptococcus pyogenes infection because it results in damage to the heart muscle and valves. Certain strains of Streptococcus pyogenes contain cell membrane antigens that cross react with human heart tissue antigens.
Fever, malaise, migratory non suppurative polyarthritis,
Evidence of inflammation of all parts of the heart.
Small perivascular granulomas in the myocardium develop (Aschoff bodies : nodules found in the heart).
Diagnostic Laboratory Tests
• Specimens: Depends on the nature of Streptococcal infection. A throat swab, pus, cerebrospinal fluid or other sterile body fluid, or blood is obtained for culture. Serum is obtained for antibody determinations.
• Smears: Of little diagnostic value.
• Culture: Specimens should be cultured on blood agar, . Incubation in 10% CO2 often speeds hemolysis. Pinpoint colony with a wide zone of β-hemolysis,
Biochemical test, and group specific antigens are confirmatory.
Catalase negative, Bacitracin sensitive and Pyrrolidonyl Arylamidase (PYR) test is positive.
Diagnostic Laboratory Tests
• Antigen detection tests: Extraction of antigen and detection by EIA.•
Diagnostic Laboratory Tests
• Serologic tests: A rise in antibody to several group A Streptococcal antigens can be estimated, anti-streptolysin O (ASO) is the most widely used.Such antibodies include ASO, particularly in respiratory disease (Anti-ASO titer is most widely used),
Antibodies to streptolysin O (ASO) titer of >200 is significant for rheumatic fever.
Anti-DNase B and antihyaluronidase, particularly in skin infections,
Anti-DNase-B Ab – Titer > 300–350 units/ml is diagnostic of PSGN and pyoderma.
• (Poststreptococcal glomerulonephritis (PSGN).
Treatment
Penicillin is the drug of choice for all type of streptococcal infections.
Pharyngitis
Benzathine penicillin G, IM single dose or oral penicillin V for 10 daysErysipelas/Cellulitis
Mild- Procaine penicillin // Severe- Penicillin G
Pneumonia and empyema
Penicillin G + drainage of empyema
Rheumatic fever
Benzathine penicillin G, IM single dose // or oral Penicillin V for 10 days
Long-term maintenance therapy with penicillin G monthly:
• For 5 yrs or until 21 yrs of age, (without carditis)• For 10 yrs (with carditis)
• Up to 40 yrs of age/lifelong (with residual heart disease)
PSGN
• Benzathine penicillin G, IM single dose // or oral Penicillin V for 10 days
Pharyngeal carrier
Penicillin V + rifampicin
Epidemiology, prevention, and control
The detection of Streptococcus pyogenes by culture or any other method should be considered serious condition;
The nasal discharge of a person carrying the organism is the most dangerous source for the spreading.